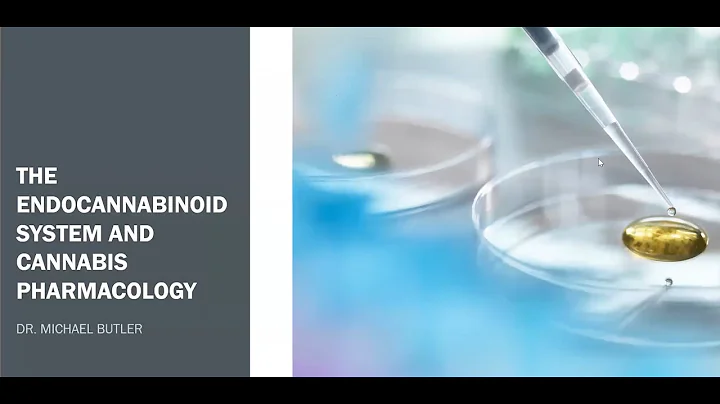
The Endocannabinoid System and Cannabis Pharmacology with Dr. Mike Butler

External Source
Cannabis And The Endocannabinoid System
Synopsis
How does cannabis work in the brain? In this video, we will discuss how cannabis products interact with the brains' ...
Download Options
Choose a download method below. All links open in new tabs.
| Service | Features | Action |
|---|---|---|
| SaveFrom |
MP4 & MP3 • HD Quality • Browser Extension Available
|
Download |
Security Notice: These are third-party services. We recommend using antivirus software and being cautious of pop-up ads.